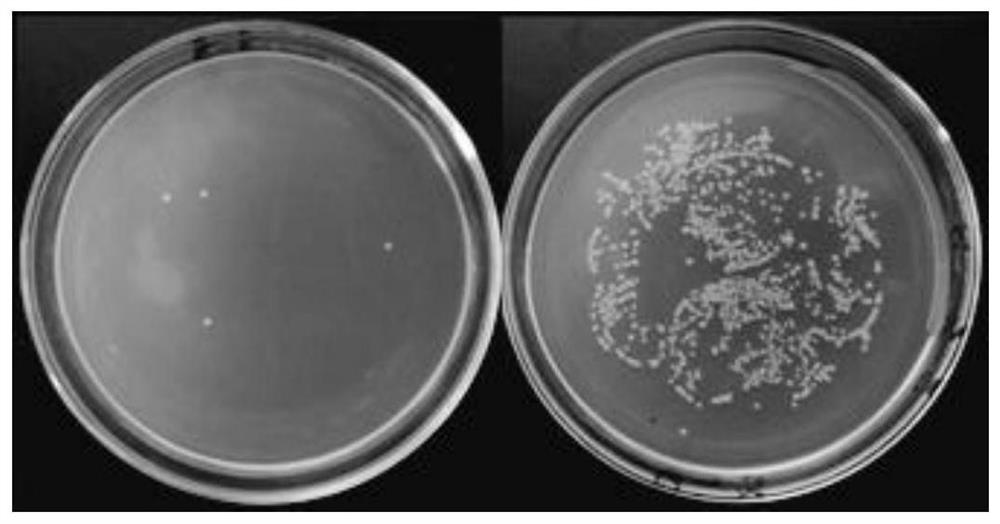
暂无图片

欢迎访问中知在线
 APP下载
APP下载
-

安卓APP下载
-

苹果APP下载
 APP下载
APP下载

安卓APP下载

苹果APP下载
| 自行实施情况 | 在先许可情况 |
|---|---|
| 未实施 | 无 |
| 许可期限届满日 | 费用类型 | 费用详情 | 其它约定事项 |
|---|---|---|---|
| 2023-12-31 | 入门费加提成费支付 | 入门费为 2000元,提成费按当年度合同产品净销售额的5 %提取。 |
本发明公开了一种含甜菜碱两性离子的两亲性高分子防雾抗菌涂层及其制备方法。该涂层是由将甲基丙烯酸烷基酯、甲基丙烯酸氨基盐酸盐与甲基丙烯酸甜菜碱经自由基聚合制备的聚(甲基丙烯酸烷基酯 co 甲基丙烯酸 2 氨基乙基酯 co 甲基丙烯酰乙基甜菜碱)与芳香多醛发生交联反应制得。其中,甜菜碱两性离子具有良好的防雾与生物相容性,甲基丙烯酸 2 氨基乙基酯具有杀菌作用,甲基丙烯酸烷基酯可赋予涂层良好的成膜性,并且可与氨基协同提高涂层的杀菌能力,芳香多醛可与部分氨基发生交联反应形成结构稳定的交联网络。本发明中的原料易得,制备简便,具有良好的防雾性、抗菌性、生物相容性以及结构稳定性,应用前景广阔⊙